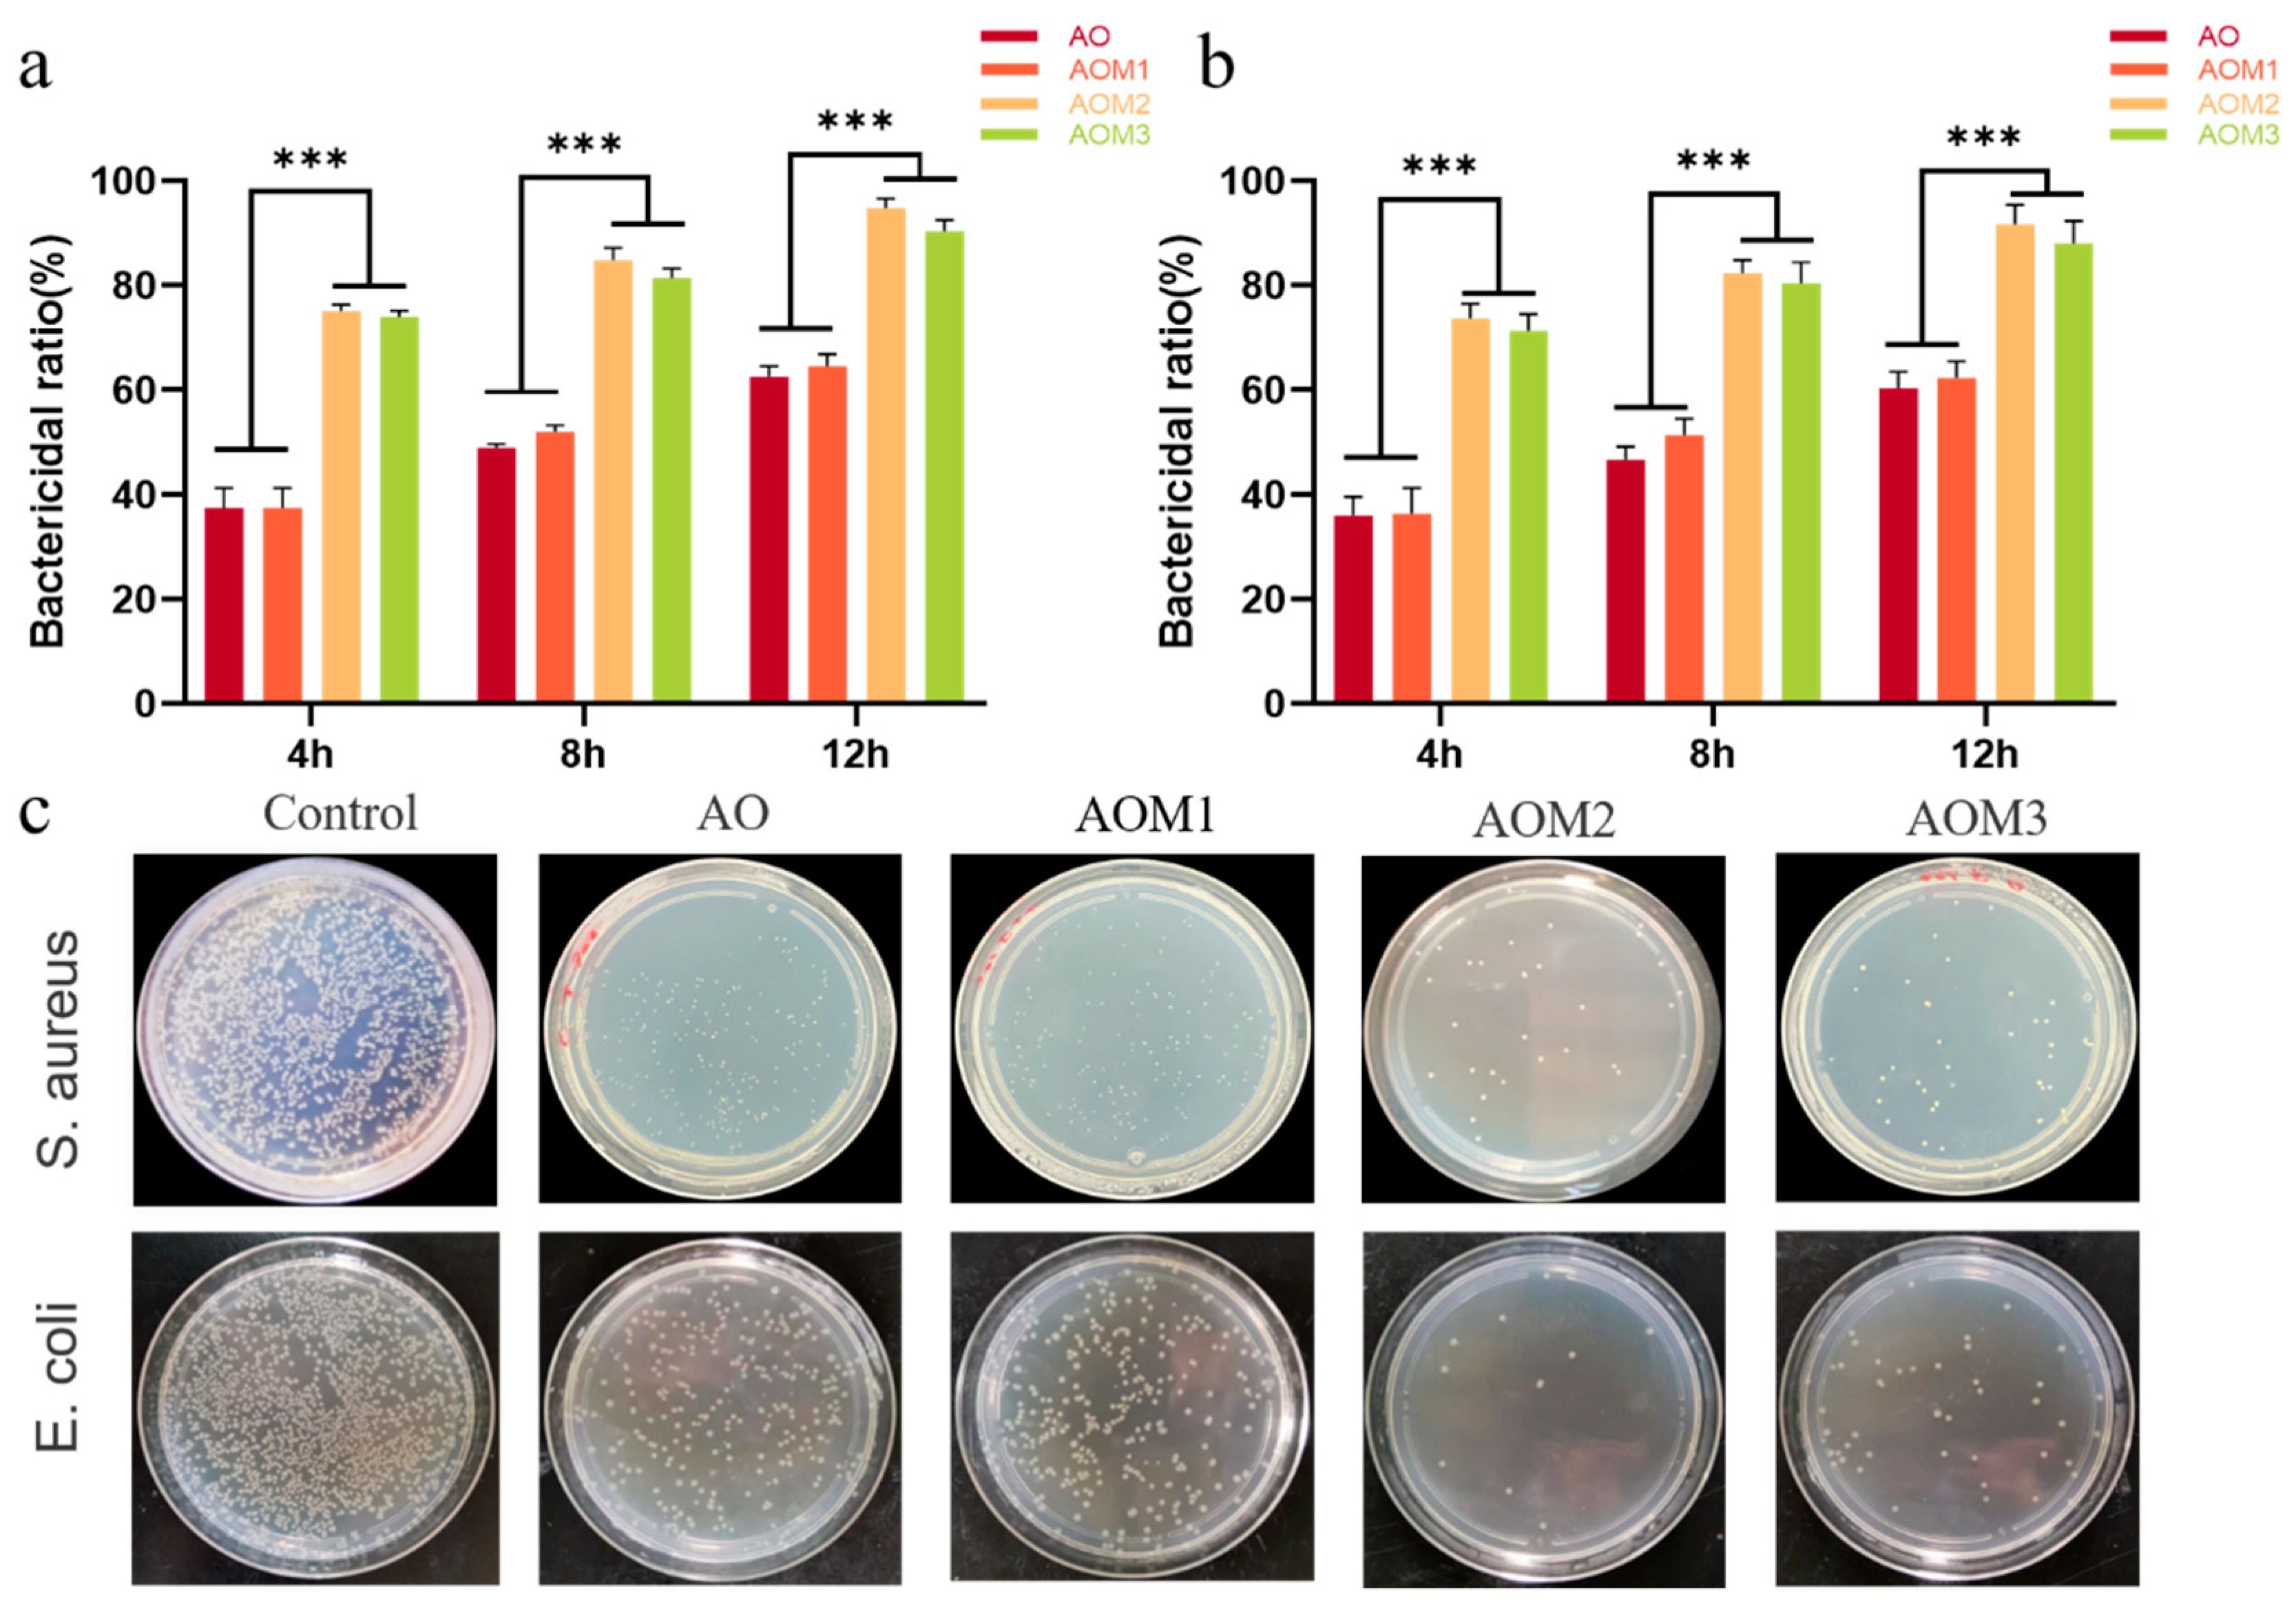
Gels 09 00455 g005 Gels 09 00455 g005

Multifunctional Oxidized Dextran Cross-Linked Alkylated Chitosan/Drug-Loaded and Silver-Doped Mesoporous Bioactive Glass Cryogel for Hemostasis of Noncompressible Wounds
Abstract
1. Introduction
2. Results and Discussion
2.1. Synthesis and Characterization of Cryogels
2.2. Mechanical and Shape Memory Properties of Cryogels
2.3. Biocompatibility and Biodegradability of Cryogels
2.4. Antibacterial Properties of Cryogels
2.5. Hemostatic Properties of Cryogels
2.6. Cryogel to Guide Liver Regeneration
3. Conclusions
4. Experimental Section
4.1. Materials
4.2. Preparation of Cryogels
4.3. Characterization of Cryogels
4.4. Characterization of Physical Properties of Cryogels
4.5. Biocompatibility of Cryogels
4.6. Whole-Blood Coagulation
4.7. Red Blood Cell and Platelet Adhesion
4.8. Biodegradability
4.9. In Vitro Antibacterial Activity
4.10. Hemostatic Properties of Cryogels
4.11. Regeneration of the Liver
4.12. Statistics and Reproducibility
Supplementary Materials
Author Contributions
Funding
Institutional Review Board Statement
Informed Consent Statement
Data Availability Statement
Conflicts of Interest
References
- Holcomb, J.B. Methods for improved hemorrhage control. Crit. Care 2004, 8, S57. [Google Scholar] [CrossRef] [PubMed]
- Spahn, D.R.; Bouillon, B.; Cerny, V.; Duranteau, J.; Filipescu, D.; Hunt, B.J.; Komadina, R.; Maegele, M.; Nardi, G.; Riddez, L.; et al. The European guideline on management of major bleeding and coagulopathy following trauma: Fifth edition. Crit. Care 2019, 23, 98. [Google Scholar] [CrossRef] [PubMed]
- Morrison, J.J.; Ross, J.D.; Houston, R.I.V.; Watson, J.D.B.; Sokol, K.K.; Rasmussen, T.E. Use of Resuscitative Endovascular Balloon Occlusion of the Aorta in a Highly Lethal Model of Noncompressible Torso Hemorrhage. Shock 2014, 41, 130–137. [Google Scholar] [CrossRef] [PubMed]
- Shoffstall, A.J.; Atkins, K.T.; Groynom, R.E.; Varley, M.E.; Everhart, L.M.; Lashof-Sullivan, M.M.; Martyn-Dow, B.; Butler, R.S.; Ustin, J.S.; Lavik, E.B. Intravenous Hemostatic Nanoparticles Increase Survival Following Blunt Trauma Injury. Biomacromolecules 2012, 13, 3850–3857. [Google Scholar] [CrossRef] [PubMed]
- Wang, D.; Li, W.; Wang, Y.; Yin, H.; Ding, Y.; Ji, J.; Wang, B.; Hao, S. Fabrication of an expandable keratin sponge for improved hemostasis in a penetrating trauma. Colloids Surf. B Biointerfaces 2019, 182, 110367. [Google Scholar] [CrossRef] [PubMed]
- Kragh, J.F., Jr.; Aden, J.K.; Steinbaugh, J.; Bullard, M.; Dubick, M.A. Gauze vs. XSTAT in wound packing for hemorrhage control. Am. J. Emerg. Med. 2015, 33, 974–976. [Google Scholar] [CrossRef] [PubMed]
- Yang, W.; Song, J.; Zhu, Y.; Ye, Z.; Wang, M.; Fang, Y.; Wu, W.; Chen, D.; Wang, Y. Application of chain-based sponge dressing for gunshot wounds in the groin. Am. J. Emerg. Med. 2021, 39, 24–27. [Google Scholar] [CrossRef]
- Li, M.; Zhang, Z.; Liang, Y.; He, J.; Guo, B. Multifunctional Tissue-Adhesive Cryogel Wound Dressing for Rapid Nonpressing Surface Hemorrhage and Wound Repair. ACS Appl. Mater. Interfaces 2020, 12, 35856–35872. [Google Scholar] [CrossRef]
- Cenni, E.; Ciapetti, G.; Stea, S.; Corradini, A.; Carozzi, F. Biocompatibility and performance in vitro of a hemostatic gelatin sponge. J. Biomater. Sci. Polym. Ed. 2000, 11, 685–699. [Google Scholar] [CrossRef]
- Wang, F.; Sun, J.; Shi, H.; Zhou, J.; Ma, X.; Song, X.; Su, X.; Liu, L. Multifunctionalized alginate/polydopamine cryogel for hemostasis, antibacteria and promotion of wound healing. Int. J. Biol. Macromol. 2023, 224, 1373–1381. [Google Scholar] [CrossRef]
- Zhao, X.; Guo, B.; Wu, H.; Liang, Y.; Ma, P.X. Injectable antibacterial conductive nanocomposite cryogels with rapid shape recovery for noncompressible hemorrhage and wound healing. Nat. Commun. 2018, 9, 2784. [Google Scholar] [CrossRef]
- Fang, Y.; Xu, Y.; Wang, Z.; Zhou, W.; Yan, L.; Fan, X.; Liu, H. 3D porous chitin sponge with high absorbency, rapid shape recovery, and excellent antibacterial activities for noncompressible wound. Chem. Eng. J. 2020, 388, 124169. [Google Scholar] [CrossRef]
- Lan, G.; Lu, B.; Wang, T.; Wang, L.; Chen, J.; Yu, K.; Liu, J.; Dai, F.; Wu, D. Chitosan/gelatin composite sponge is an absorbable surgical hemostatic agent. Colloids Surf. B Biointerfaces 2015, 136, 1026–1034. [Google Scholar] [CrossRef] [PubMed]
- Yang, X.; Liu, W.; Li, N.; Wang, M.; Liang, B.; Ullah, I.; Luis Neve, A.; Feng, Y.; Chen, H.; Shi, C. Design and development of polysaccharide hemostatic materials and their hemostatic mechanism. Biomater. Sci. 2017, 5, 2357–2368. [Google Scholar] [CrossRef] [PubMed]
- Hou, S.; Liu, Y.; Feng, F.; Zhou, J.; Feng, X.; Fan, Y. Polysaccharide-Peptide Cryogels for Multidrug-Resistant-Bacteria Infected Wound Healing and Hemostasis. Adv. Healthc. Mater. 2020, 9, e1901041. [Google Scholar] [CrossRef]
- Sun, X.; Tang, Z.; Pan, M.; Wang, Z.; Yang, H.; Liu, H. Chitosan/kaolin composite porous microspheres with high hemostatic efficacy. Carbohydr. Polym. 2017, 177, 135–143. [Google Scholar] [CrossRef]
- Wu, Z.; Tang, S.; Deng, W.; Luo, J.; Wang, X. Antibacterial chitosan composite films with food-inspired carbon spheres immobilized AgNPs. Food Chem. 2021, 363, 130342. [Google Scholar] [CrossRef]
- Sun, X.; Li, J.; Shao, K.; Su, C.; Bi, S.; Mu, Y.; Zhang, K.; Cao, Z.; Wang, X.; Chen, X.; et al. A composite sponge based on alkylated chitosan and diatom-biosilica for rapid hemostasis. Int. J. Biol. Macromol. 2021, 182, 2097–2107. [Google Scholar] [CrossRef]
- Chen, Z.; Yao, X.; Liu, L.; Guan, J.; Liu, M.; Li, Z.; Yang, J.; Huang, S.; Wu, J.; Tian, F.; et al. Blood coagulation evaluation of N-alkylated chitosan. Carbohydr. Polym. 2017, 173, 259–268. [Google Scholar] [CrossRef]
- Ma, C.; Zhao, J.; Zhu, C.; Jiang, M.; Ma, P.; Mi, Y.; Fan, D. Oxidized dextran crosslinked polysaccharide/protein/polydopamine composite cryogels with multiple hemostatic efficacies for noncompressible hemorrhage and wound healing. Int. J. Biol. Macromol. 2022, 215, 675–690. [Google Scholar] [CrossRef]
- Zhang, Y.; Guan, J.; Wu, J.; Ding, S.; Yang, J.; Zhang, J.; Dong, A.; Deng, L. N-alkylated chitosan/graphene oxide porous sponge for rapid and effective hemostasis in emergency situations. Carbohydr. Polym. 2019, 219, 405–413. [Google Scholar] [CrossRef] [PubMed]
- Du, X.; Wu, L.; Yan, H.; Jiang, Z.; Li, S.; Li, W.; Bai, Y.; Wang, H.; Cheng, Z.; Kong, D.; et al. Microchannelled alkylated chitosan sponge to treat noncompressible hemorrhages and facilitate wound healing. Nat. Commun. 2021, 12, 4733. [Google Scholar] [CrossRef] [PubMed]
- Yao, L.; Gao, H.; Lin, Z.; Dai, Q.; Zhu, S.; Li, S.; Liu, C.; Feng, Q.; Li, Q.; Wang, G.; et al. A shape memory and antibacterial cryogel with rapid hemostasis for noncompressible hemorrhage and wound healing. Chem. Eng. J. 2022, 428, 131005. [Google Scholar] [CrossRef]
- Naseri, S.; Lepry, W.C.; Nazhat, S.N. Bioactive glasses in wound healing: Hope or hype? J. Mater. Chem. B 2017, 5, 6167–6174. [Google Scholar] [CrossRef] [PubMed]
- Pajares-Chamorro, N.; Wagley, Y.; Maduka, C.V.; Youngstrom, D.W.; Yeger, A.; Badylak, S.F.; Hammer, N.D.; Hankenson, K.; Chatzistavrou, X. Silver-doped bioactive glass particles for in vivo bone tissue regeneration and enhanced methicillin-resistant Staphylococcus aureus (MRSA) inhibition. Mater. Sci. Eng. C 2021, 120, 111693. [Google Scholar] [CrossRef]
- Dai, C.; Yuan, Y.; Liu, C.; Wei, J.; Hong, H.; Li, X.; Pan, X. Degradable, antibacterial silver exchanged mesoporous silica spheres for hemorrhage control. Biomaterials 2009, 30, 5364–5375. [Google Scholar] [CrossRef]
- Lazaridou, M.; Christodoulou, E.; Nerantzaki, M.; Kostoglou, M.; Lambropoulou, D.A.; Katsarou, A.; Pantopoulos, K.; Bikiaris, D.N. Formulation and In-Vitro Characterization of Chitosan-Nanoparticles Loaded with the Iron Chelator Deferoxamine Mesylate (DFO). Pharmaceutics 2020, 12, 238. [Google Scholar] [CrossRef]
- Zhu, H.; Zheng, K.; Boccaccini, A.R. Multi-functional silica-based mesoporous materials for simultaneous delivery of biologically active ions and therapeutic biomolecules. Acta Biomater. 2021, 129, 1–17. [Google Scholar] [CrossRef]
- Kim, I.; Lee, S.S.; Bae, S.; Lee, H.; Hwang, N.S. Heparin Functionalized Injectable Cryogel with Rapid Shape-Recovery Property for Neovascularization. Biomacromolecules 2018, 19, 2257–2269. [Google Scholar] [CrossRef] [PubMed]
- Huang, Y.; Zhao, X.; Zhang, Z.; Liang, Y.; Yin, Z.; Chen, B.; Bai, L.; Han, Y.; Guo, B. Degradable Gelatin-Based IPN Cryogel Hemostat for Rapidly Stopping Deep Noncompressible Hemorrhage and Simultaneously Improving Wound Healing. Chem. Mater. 2020, 32, 6595–6610. [Google Scholar] [CrossRef]
- Sultankulov, B.; Berillo, D.; Kauanova, S.; Mikhalovsky, S.; Mikhalovska, L.; Saparov, A. Composite Cryogel with Polyelectrolyte Complexes for Growth Factor Delivery. Pharmaceutics 2019, 11, 650. [Google Scholar] [CrossRef]
- Shirbin, S.J.; Lam, S.J.; Chan, N.J.; Ozmen, M.M.; Fu, Q.; O’Brien-Simpson, N.; Reynolds, E.C.; Qiao, G.G. Polypeptide-Based Macroporous Cryogels with Inherent Antimicrobial Properties: The Importance of a Macroporous Structure. ACS Macro Lett. 2016, 5, 552–557. [Google Scholar] [CrossRef]
- Huang, Y.; Zhao, X.; Wang, C.; Chen, J.; Liang, Y.; Li, Z.; Han, Y.; Guo, B. High-strength anti-bacterial composite cryogel for lethal noncompressible hemorrhage hemostasis: Synergistic physical hemostasis and chemical hemostasis. Chem. Eng. J. 2022, 427, 131977. [Google Scholar] [CrossRef]
- Gao, C.; Wang, Y.; Shi, J.; Wang, Y.; Huang, X.; Chen, X.; Chen, Z.; Xie, Y.; Yang, Y. Superamphiphilic Chitosan Cryogels for Continuous Flow Separation of Oil-In-Water Emulsions. ACS Omega 2022, 7, 5937–5945. [Google Scholar] [CrossRef] [PubMed]
- Wilems, T.S.; Lu, X.; Kurosu, Y.E.; Khan, Z.; Lim, H.J.; Smith Callahan, L.A. Effects of free radical initiators on polyethylene glycol dimethacrylate hydrogel properties and biocompatibility. J. Biomed. Mater. Res. A 2017, 105, 3059–3068. [Google Scholar] [CrossRef]
- Yang, X.; Chen, M.; Li, P.; Ji, Z.; Wang, M.; Feng, Y.; Shi, C. Fabricating poly(vinyl alcohol)/gelatin composite sponges with high absorbency and water-triggered expansion for noncompressible hemorrhage and wound healing. J. Mater. Chem. B 2021, 9, 1568–1582. [Google Scholar] [CrossRef]
- Liu, Y.; Xu, K.; Chang, Q.; Darabi, M.A.; Lin, B.; Zhong, W.; Xing, M. Highly Flexible and Resilient Elastin Hybrid Cryogels with Shape Memory, Injectability, Conductivity, and Magnetic Responsive Properties. Adv. Mater. 2016, 28, 7758–7767. [Google Scholar] [CrossRef] [PubMed]
- Li, Z.; Man, J.; Wang, X.; Zhang, Y. Biodegradable Sodium Alginate/Carrageenan/Cellulose Composite Hydrogel Wound Dressings Containing Herbal Extracts for Promoting Blood Coagulation and Wound Healing. Macromol. Biosci. 2023, 23, e2200235. [Google Scholar] [CrossRef] [PubMed]

Disclaimer/Publisher’s Note: The statements, opinions and data contained in all publications are solely those of the individual author(s) and contributor(s) and not of MDPI and/or the editor(s). MDPI and/or the editor(s) disclaim responsibility for any injury to people or property resulting from any ideas, methods, instructions or products referred to in the content. |
© 2023 by the authors. Licensee MDPI, Basel, Switzerland. This article is an open access article distributed under the terms and conditions of the Creative Commons Attribution (CC BY) license (https://creativecommons.org/licenses/by/4.0/).
Share and Cite
Lei, D.; Zhao, J.; Zhu, C.; Jiang, M.; Ma, P.; Mi, Y.; Fan, D. Multifunctional Oxidized Dextran Cross-Linked Alkylated Chitosan/Drug-Loaded and Silver-Doped Mesoporous Bioactive Glass Cryogel for Hemostasis of Noncompressible Wounds. Gels 2023, 9, 455. https://doi.org/10.3390/gels9060455
Lei D, Zhao J, Zhu C, Jiang M, Ma P, Mi Y, Fan D. Multifunctional Oxidized Dextran Cross-Linked Alkylated Chitosan/Drug-Loaded and Silver-Doped Mesoporous Bioactive Glass Cryogel for Hemostasis of Noncompressible Wounds. Gels. 2023; 9(6):455. https://doi.org/10.3390/gels9060455
Chicago/Turabian StyleLei, Dong, Jing Zhao, Chenhui Zhu, Min Jiang, Pei Ma, Yu Mi, and Daidi Fan. 2023. "Multifunctional Oxidized Dextran Cross-Linked Alkylated Chitosan/Drug-Loaded and Silver-Doped Mesoporous Bioactive Glass Cryogel for Hemostasis of Noncompressible Wounds" Gels 9, no. 6: 455. https://doi.org/10.3390/gels9060455
APA StyleLei, D., Zhao, J., Zhu, C., Jiang, M., Ma, P., Mi, Y., & Fan, D. (2023). Multifunctional Oxidized Dextran Cross-Linked Alkylated Chitosan/Drug-Loaded and Silver-Doped Mesoporous Bioactive Glass Cryogel for Hemostasis of Noncompressible Wounds. Gels, 9(6), 455. https://doi.org/10.3390/gels9060455

